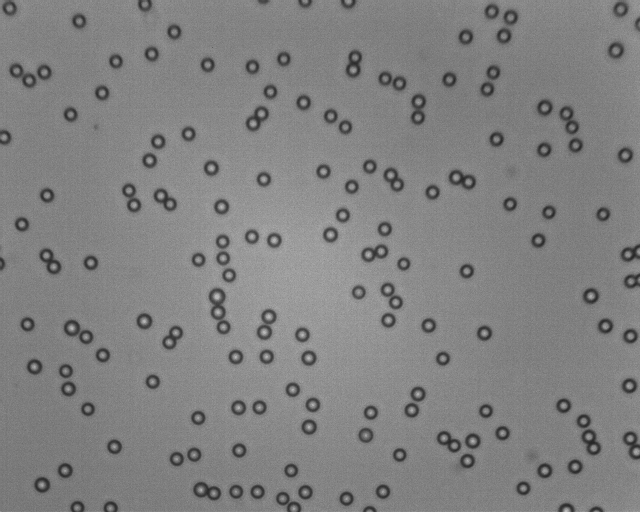

一、儀器簡介:
Rise-3002型顆粒圖像分析儀將傳統(tǒng)的測量方法與現(xiàn)代的圖像技術(shù)相結(jié)合,是一種采用圖像法進(jìn)行顆粒形貌分析和粒度測量的顆粒分析系統(tǒng),由光學(xué)顯微鏡、數(shù)字CCD攝像機(jī)和顆粒圖像處理分析軟件組成。該系統(tǒng)通過用的數(shù)字?jǐn)z像機(jī)將顆粒在顯微鏡下的圖像拍攝下來傳輸給電腦,通過顆粒圖像處理分析軟件對圖像進(jìn)行處理分析,具有直觀、形象、準(zhǔn)確和測試范圍寬等特點。可以觀察顆粒形貌,也可得到粒度分布等分析結(jié)果。
Rise-3002型顆粒圖像分析儀融合了當(dāng)今先進(jìn)的圖像處理和分析技術(shù),產(chǎn)品設(shè)計符合標(biāo)準(zhǔn)ISO-13322-1,可完成幾十項顆粒幾何形態(tài)學(xué)的參數(shù)測量和圖像幾何形狀的測量。軟件同時配備數(shù)據(jù)報表,可直接按顆粒的粒徑面積、形狀等多類參數(shù),以線性或非線性統(tǒng)計方式繪出分布圖。
二、技術(shù)參數(shù):
1.量程范圍:1~3000μm;
2.最大光學(xué)放大倍數(shù):1600倍。
3.顯微鏡:光學(xué)顯微鏡
4.最大分辨率:0.1μm/像素;
5.準(zhǔn)確性及重復(fù)性誤差:<3%;
6.數(shù)字?jǐn)z像機(jī)(CCD):500萬像素;
7.自動分割速度:≤1秒;
8.分割成功率:≥97%;
9.儀器和工控平板電腦一體化設(shè)計,避免了儀器軟件以及硬件的長久使用中的丟失,極大提高了設(shè)備使用期和穩(wěn)定性。
三、應(yīng)用范圍:
適用于磨料、涂料、非金屬礦、化學(xué)試劑、粉塵、填料等各種粉末顆粒的粒度測量、形貌觀察和分析
四、軟件功能:

1、 可以對圖像進(jìn)行多種處理。如:影像增強(qiáng)、圖像疊加、局部提取、定倍放大、對比度、亮度調(diào)節(jié)等幾十種功能
2、 具有圓度、曲線、周長、面積、直徑等幾十種幾何參數(shù)的基本測量
3、 可直接按顆粒粒徑的粒徑面積、形狀等多類參數(shù),以線性或非線性統(tǒng)計方式繪出分布圖
數(shù)據(jù)輸出:
周長分布、面積分布、長徑分布、短徑分布、周長相當(dāng)徑分布、面積相當(dāng)徑分布、Feret徑分布、圓度、中間徑(D50)、有效粒徑(D10)、限定粒徑(D60)、D30、D97、個數(shù)長度平均徑、個數(shù)面積平均徑、個數(shù)體積平均徑、長度面積平均徑、長度體積平均徑、面積體積平均徑、不均勻系數(shù)、曲率系數(shù)。
五、技術(shù)支持:
全面的技術(shù)培訓(xùn)和內(nèi)容詳盡的使用操作說明書、軟件在線幫助使操作人員能準(zhǔn)確操作、解決疑問、排除故障。
根據(jù)樣品的密度、粒度、流動性、團(tuán)聚性、溶解性和物理化學(xué)反應(yīng)等理化特性,我們總結(jié)出了一套科學(xué)、系統(tǒng)和完整的分散測試方案,隨著儀器提供給用戶。我們既銷售儀器,又提供分散測試方案。
六、Rise-3002型顆粒圖像分析儀分析報告:
送檢單位: | 濟(jì)南潤之科技有限公司 | |||||
測試單位: | 濟(jì)南潤之科技有限公司 | |||||
樣品名稱: | 002 | |||||
綜 述 報 告 | ||||||
平均徑 | 周長徑um | 面積徑um | 長徑um | 短徑um | 0度FERET徑um | 90度FERET徑um |
個數(shù)長度平均徑 | 3.937 | 3.553 | 3.689 | 3.217 | 3.494 | 3.571 |
個數(shù)面積平均徑 | 3.945 | 3.558 | 3.696 | 3.224 | 3.5 | 3.578 |
個數(shù)體積平均徑 | 3.954 | 3.563 | 3.703 | 3.23 | 3.506 | 3.584 |
長度面積平均徑 | 3.954 | 3.563 | 3.702 | 3.23 | 3.506 | 3.584 |
長度體積平均徑 | 3.962 | 3.568 | 3.71 | 3.237 | 3.512 | 3.591 |
面積體積平均徑 | 3.971 | 3.573 | 3.717 | 3.244 | 3.519 | 3.597 |
D5 | 3.55 | 3.16 | 3.39 | 2.88 | 3.16 | 0.87 |
D10(有效徑) | 3.55 | 3.31 | 3.39 | 2.95 | 3.16 | 3.31 |
D30(限定徑) | 3.8 | 3.47 | 3.55 | 3.09 | 3.24 | 3.47 |
D50(中間徑) | 3.89 | 3.47 | 3.55 | 3.16 | 3.47 | 3.55 |
D60 | 3.89 | 3.55 | 3.72 | 3.31 | 3.47 | 3.55 |
D90 | 4.27 | 3.8 | 3.98 | 3.47 | 3.72 | 3.8 |
D97 | 4.47 | 3.98 | 4.17 | 3.72 | 3.89 | 4.07 |
不均勻系數(shù) | 1.096 | 1.073 | 1.097 | 1.122 | 1.098 | 1.073 |
曲率系數(shù) | 15.823 | 12.914 | 13.829 | 10.713 | 11.527 | 12.914 |

咨詢熱線:010-62923342
咨詢熱線:010-62923342






